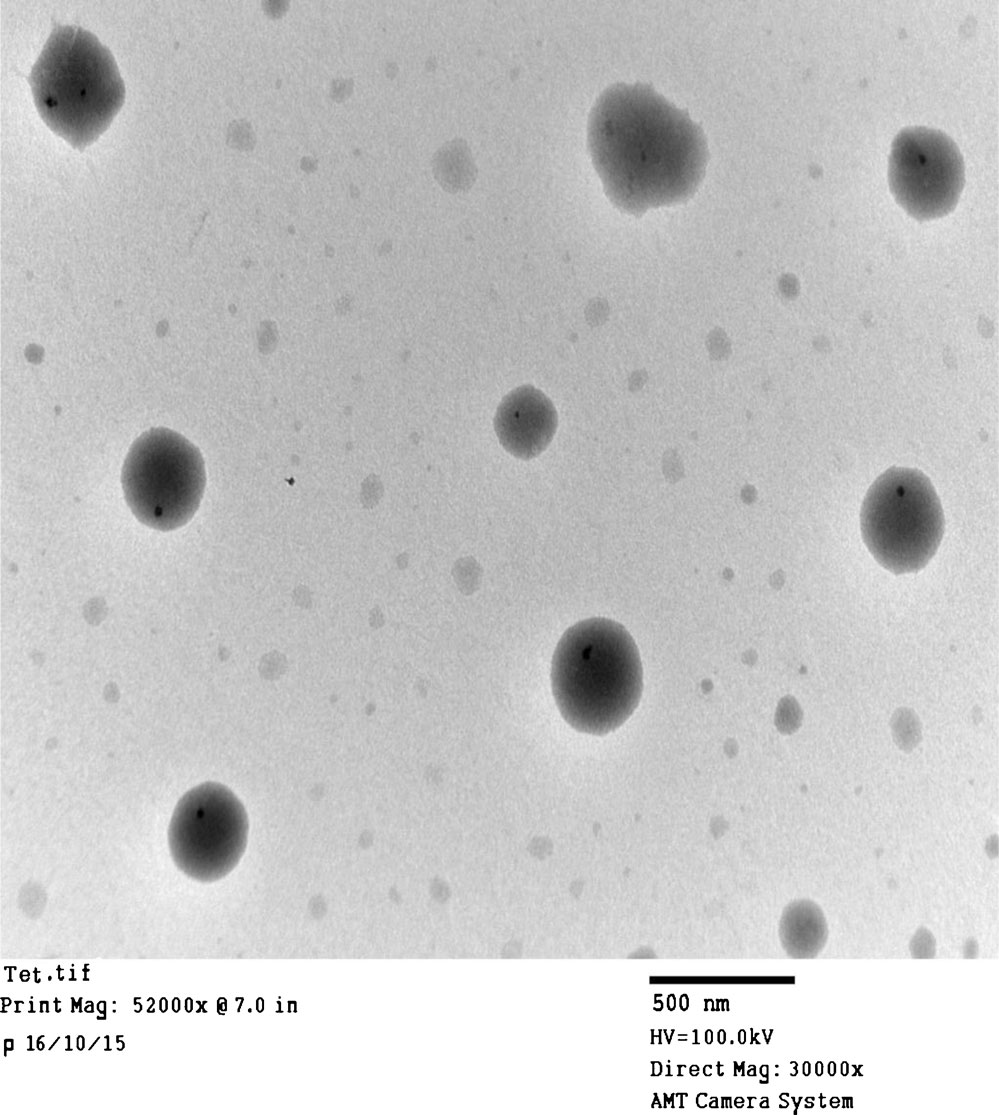
07_Feb_Pubs_Garg.jpg

The AAPS PharmSciTech High Impact Article Award was presented at the 2019 AAPS PharmSci 360.
The 2019 AAPS PharmSciTech High Impact Article Award was presented to Harmanpreet Singh, Varun Garg, Amit Bhatia, Kaisar Raza, Sachin Kumar Singh, Bhupinder Singh, and Sarwar Beg for their article Systematic Development of Transethosomal Gel System of Piroxicam: Formulation Optimization, In Vitro Evaluation, and Ex Vivo Assessment. This article was first published online on February 11, 2016. Since then, it has received more than 4,000 downloads and 21 citations.
TEM image of optimized transethosomal formulation (OP) at x30,000. (doi 10.1208/s12249-016-0489-z)
Abstract
Piroxicam is used in the treatment of rheumatoid arthritis, osteoarthritis, and other inflammatory diseases. Upon oral administration, it is reported to cause ulcerative colitis, gastrointestinal irritation, edema and peptic ulcer. Hence, an alternative delivery system has been designed in the form of transethosome. The present study describes the preparation, optimization, characterization, and ex vivo study of piroxicam-loaded transethosomal gel using the central composite design. On the basis of the prescreening study, the concentration of lipids and ethanol was kept in the range of 2–4% w/v and 0–40% v/v, respectively. Formulation was optimized by measuring drug retention in the skin, drug permeation, entrapment efficiency, and vesicle size. Optimized formulation was incorporated in hydrogel and compared with other analogous vesicular (liposomes, ethosomes, and transfersomes) gels for the aforementioned responses. Among the various lipids used, soya phosphatidylcholine (SPL 70) and ethanol in various percentages were found to affect drug retention in the skin, drug permeation, vesicle size, and entrapment efficiency. The optimized batch of transethosome has shown 392.730 μg cm−2 drug retention in the skin, 44.312 μg cm−2 h−1 drug permeation, 68.434% entrapment efficiency, and 655.369 nm vesicle size, respectively. It was observed that the developed transethosomes were found superior in all the responses as compared to other vesicular formulations with improved stability and highest elasticity. Similar observations were noted with its gel formulation.